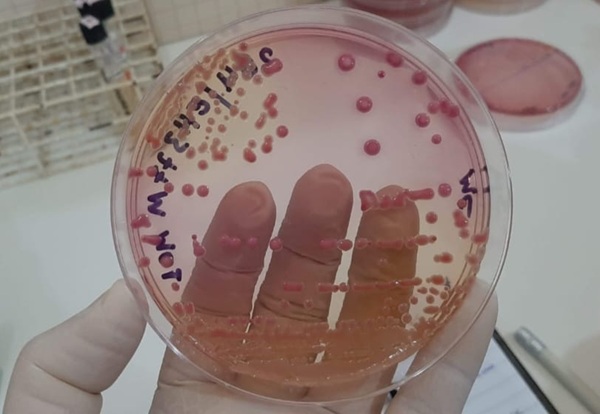
Fiocruz e Cepen investigam RAM de bactérias Klebsiella e Pseudomonas aeruginosa

Pesquisadores da Fiocruz e do Centro de Pesquisa em Medicina Tropical (Cepem) de Rondônia identificaram espécies bacterianas e investigaram o perfil de resistência aos antibióticos de bactérias do gênero Klebsiella e Pseudomonas aeruginosa, inseridas na lista global da Organização Mundial de Saúde (OMS) como microrganismos de importância para a saúde pública. A apresentação dos resultados foi organizada em colaboração com o Instituto de Educação em Saúde Pública de Rondônia (Iespro).
O estudo Avaliação da resistência aos antimicrobianos de bactérias patogênicas isoladas de amostras clínicas, ambientais e de efluentes hospitalares na região de Porto Velho-RO, demonstrou que houve maior prevalência de colonização de Klebsiella spp. e Pseudomonas aeruginosa na cavidade bucal e axila de pacientes hospitalizados, bem como em leitos no caso das superfícies hospitalares.
As bactérias do gênero Klebsiella, que foram mais frequentes na cavidade nasal, houve um quantitativo maior de bactérias resistentes (acima de 50%) a antibióticos da classe das cefalosporinas e fluoroquinolonas (ciprofloxacina e levofloxacina), principalmente em amostras coletadas de superfícies hospitalares e pacientes hospitalizados. Enquanto nas amostras provenientes de profissionais de saúde, a quantidade de microrganismos resistentes foi consideravelmente menor. Além disso, as bactérias foram mais sensíveis a polimixina B (94,3%) e aos carbapenêmicos (acima de 70%).
Em hospitais
A pesquisa avaliou a disseminação de bactérias multirresistentes em ambiente hospitalar, pacientes hospitalizados em UTIs, profissionais de saúde intensiva e superfícies hospitalares como piso, leitos, aparelhos de ventilação mecânica, bancadas, torneiras e lavatórios ou pias.
No ambiente hospitalar as bactérias tendem a ser mais resistentes devido ao maior uso de antibióticos e podem se espalhar com maior facilidade dentro e entre unidades de saúde, por meio do contato pessoa a pessoa, mãos contaminadas de profissionais de saúde ou superfícies contaminadas, ocasionando infecções relacionadas à assistência à saúde (Iras), anteriormente conhecidas como infecções hospitalares.
Quanto ao estudo com Pseudomonas aeruginosa, os pesquisadores identificaram que essas bactérias apresentaram maior taxa de resistência aos carbapenêmicos, sendo 33,7% resistentes ao imipenem e 29,6% ao meropenem, havendo maior sensibilidade aos antibióticos piperaciclina-tazobactam; ceftolozane-tazobactam e ceftazidima-avibactam, com percentuais superiores a 80%.
Com base na análise do DNA de Pseudomonas aeruginosa também foi possível comprovar que houve a colonização de pacientes com clones multirresistentes encontrados em superfícies hospitalares e em outros pacientes, além de ocorrer a disseminação desses clones entre diferentes hospitais de Porto Velho. O clone de Pseudomonas aeruginosa mais prevalente foi o ST3079, reportado anteriormente pela primeira vez no Rio de Janeiro, tendo ocasionado surtos.
“Essas são ações pontuais que podem minimizar os impactos ao sistema público de saúde e aos pacientes que necessitam de atendimento médico e hospitalar, além de fornecer aos gestores públicos dados concretos sobre a situação desse grave problema de saúde pública, considerando os desafios e as necessidades da saúde em nossa região”, conclui Najla Matos, chefe do Laboratório de Biologia de Microrganismos da Fiocruz Rondônia. (Com informações da Agência Fiocruz – 15.07.2025)